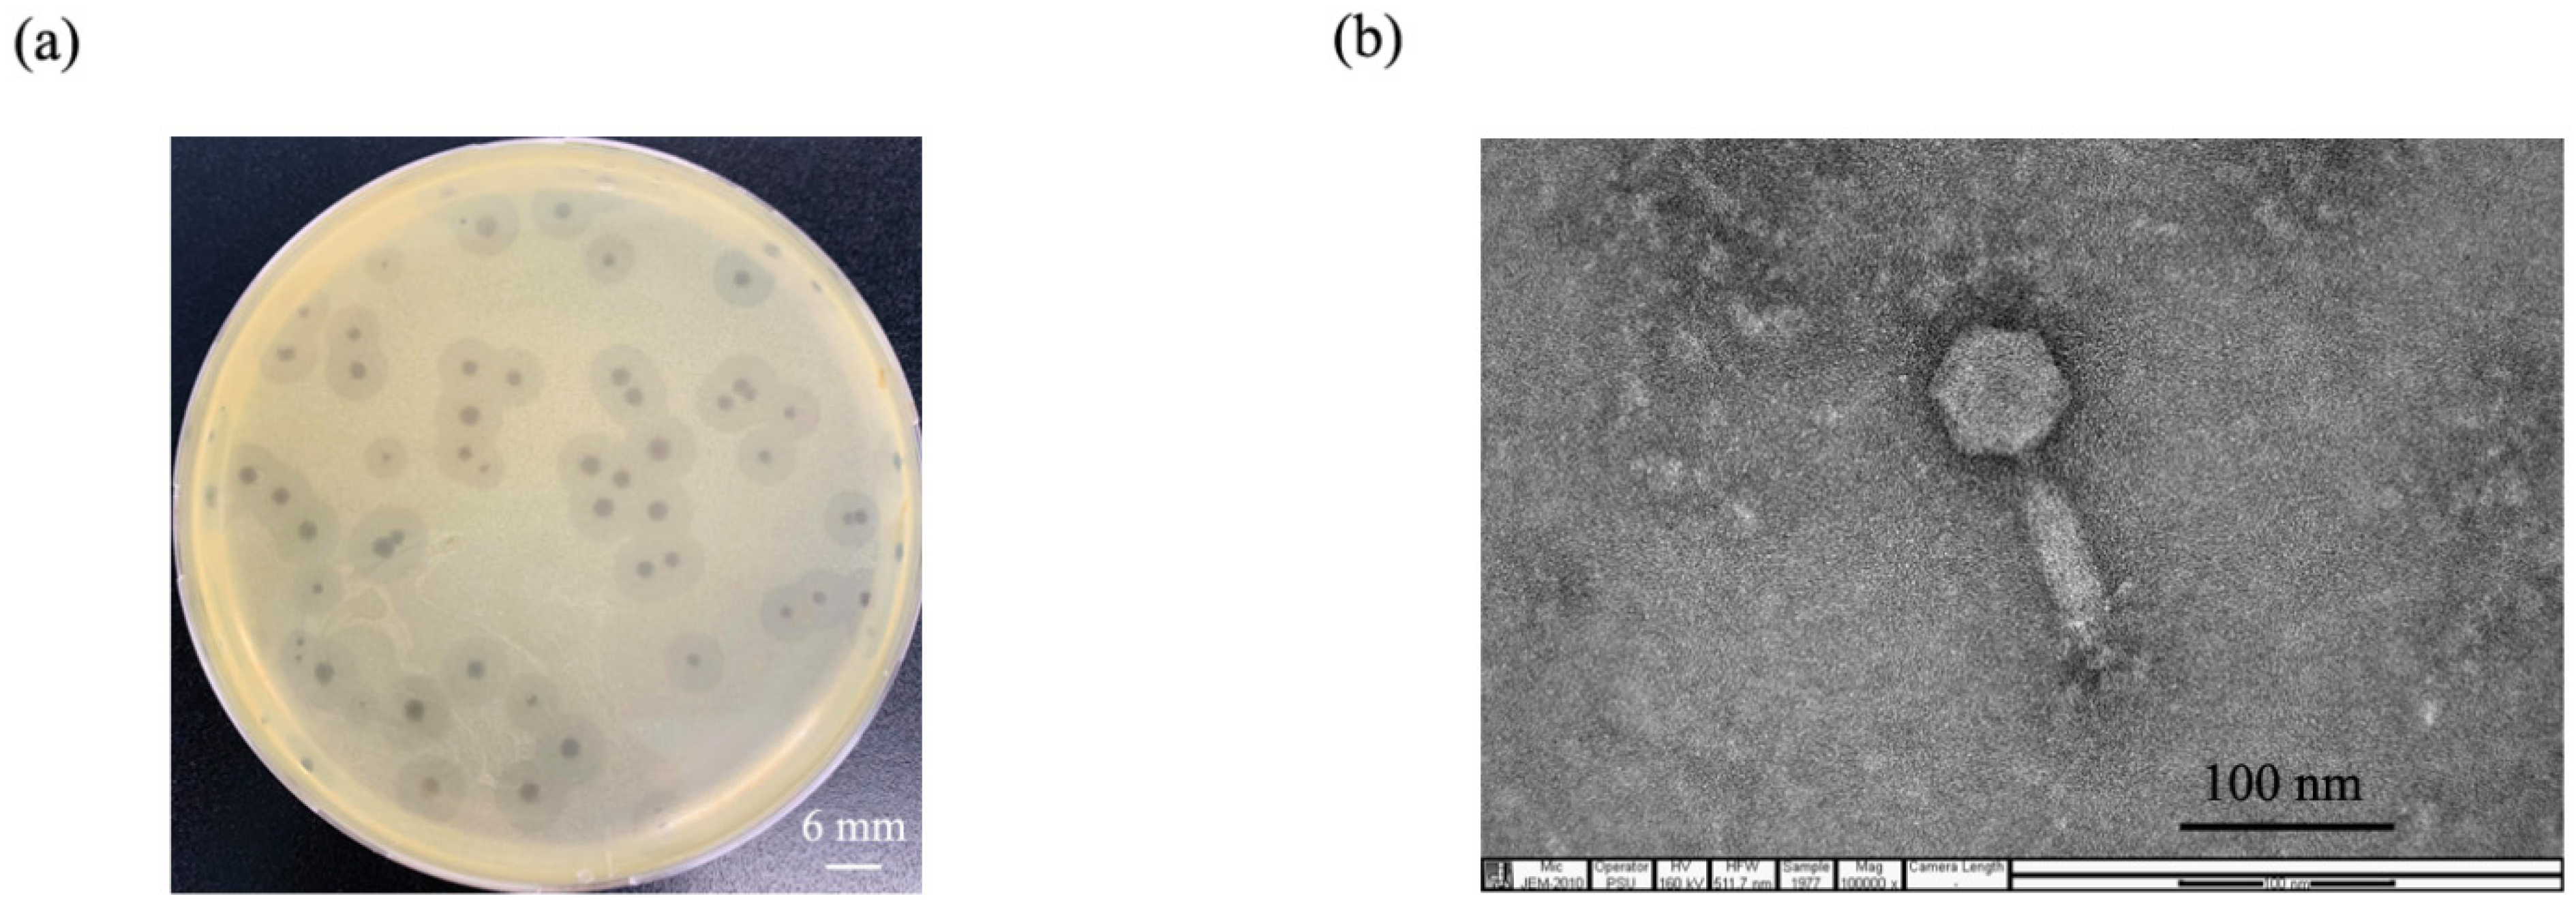
Pharmaceuticals 15 00291 g001

Characterization of Novel Lytic Myoviridae Phage Infecting Multidrug-Resistant Acinetobacter baumannii and Synergistic Antimicrobial Efficacy between Phage and Sacha Inchi Oil
Abstract
:1. Introduction
2. Results
2.1. Phage Isolation and Purification
2.2. Phage Morphology
2.3. Host Range Analysis and Efficacy of Plating (EOP)
2.4. Whole-Genome Analysis and Annotation
2.5. Analysis of the Phage Adsorption Rate and One-Step Growth Curve
2.6. Lytic Activity
2.7. Transmission Electron Microscopy (TEM) of Phage Infected Bacteria
2.8. Thermal and pH Stability Test
2.9. UV Stability Test
2.10. Antibiofilm Activity of Phage vWUPSU
2.11. Phage Sensitivity to Sacha Inchi Oil
2.12. Combined Application of Sacha Inchi Oil and Phage
2.13. Bacteriolytic Activity of the Combination of Phage vWUPSU and Sacha Inchi Oil
2.14. Evaluation of the Efficacy of the Combined vWUPSU and Sacha Inchi Oil under SEM
2.15. Antibiofilm Activity of the Combination of Phage vWUPSU and Sacha Inchi Oil
3. Discussion
4. Materials and Methods
4.1. Bacterial Strains and Growth Conditions
4.2. Isolation of Phage
4.3. Conventional Double-Layer Agar Method
4.4. Phage Purification
4.5. Phage Stock Preparation
4.6. Determination of Phage Titer
4.7. Phage Morphology under Transmission Electron Microscopy (TEM)
4.8. Phage Host Range Testing
4.9. EOP
4.10. Whole Genome Analysis
4.11. Phylogenetic Tree of Genes
4.12. Phage Adsorption Rate Assay
4.13. One Step Growth Curve
4.14. Bacterial Cell Killing Assay
4.15. TEM Study of the Morphology of Phage-Infected Bacteria
4.16. Assessment of Phage Stability under Thermal and pHs
4.17. Impact of UV Radiation on Phage Stability
4.18. Antibiofilm Activities of Phage vWUPSU
4.19. Evaluation of Phage Sensitivity to Sacha Inchi Oil
4.20. Determination of the MIC and MBC Values of Sacha Inchi Oil against MDR A. baumannii
4.21. Combination of Sacha Inchi Oil and Phage vWUPSU for Bactericidal Assay
4.22. Killing Kinetics of the Antibacterial Activity of Phage vWUPSU and Sacha Inchi Oil Combination
4.23. Effects of Combined Phage vWUPSU and Sacha Inchi Oil on Bacterial Morphology under Scanning Electron Microscopy (SEM)
4.24. Antibiofilm Activity of Phage vWUPSU and Sacha Inchi Oil Combination
4.25. SEM Analysis of Biofilms
4.26. Statistical Analyses
4.27. Accession Number
5. Conclusions
Supplementary Materials
Author Contributions
Funding
Institutional Review Board Statement
Informed Consent Statement
Data Availability Statement
Acknowledgments
Conflicts of Interest
References
- Maragakis, L.L.; Perl, T.M. Acinetobacter baumannii: Epidemiology, antimicrobial resistance, and treatment options. Clin. Infect. Dis. 2008, 46, 1254–1263. [Google Scholar] [CrossRef] [PubMed] [Green Version]
- Ellis, D.; Cohen, B.; Liu, J.; Larson, E. Risk factors for hospital-acquired antimicrobial-resistant infection caused by Acinetobacter baumannii. Antimicrob. Resist. Infect. Control 2015, 4, 40. [Google Scholar] [CrossRef] [PubMed] [Green Version]
- WHO. WHO Publishes List of Bacteria for Which New Antibiotics Are Urgently Needed; World Health Organization: Geneva, Switzerland, 2017.
- Abdul-Hassan, H.S.; El-Tahan k Massoud, B.; Gomaa, R. Bacteriophage therapy of pseudomonas burn wound sepsis. Ann. Medit. Burn Club 1990, 3, 262–264. [Google Scholar]
- Timoshchuk, I.I.; Natsiashvili, E.; Chanishvili, T.G.; Meladze, G.D. Experience with bacteriophage therapy in nonspecific suppurative lung diseases. Grudn. Khir. 1985, 2, 11–13. [Google Scholar]
- Meladze, G.D.; Mebuke, M.G.; Chkhetiia, N.; Kiknadze, N.; Koguashvili, G.G. Efficacy of staphylococcal bacteriophage in the treatment of purulent lung and pleural diseases. Grudn. Khir. 1982, 1, 53–56. [Google Scholar]
- Shabalova, I.A.; Karpanov, N.I.; Krylov, V.N.; Sharibjanova, T.O.; Akhverdijan, V.Z. Pseudomonas aeruginosa bacteriophage in treatment of P. aeruginosa infection in cystic fibrosis patients. In Proceedings of the IX International Cystic Fibrosis Congress, Brighton, UK, 9–15 June 1984; International Cystic Fibrosis Association: Zurich, Switzerland, 1995; p. 443. [Google Scholar]
- Lin, D.M.; Koskella, B.; Lin, H.C. Phage therapy: An alternative to antibiotics in the age of multi-drug resistance. World J. Gastrointest. Pharmacol. Ther. 2017, 8, 162–173. [Google Scholar] [CrossRef] [PubMed]
- Abedon, S.T.; Danis-Wlodarczyk, K.M.; Alves, D.R. Phage Therapy in the 21st Century: Is There Modern, Clinical Evidence of Phage-Mediated Efficacy? Pharmaceuticals 2021, 14, 1157. [Google Scholar] [CrossRef]
- Parasion, S.; Kwiatek, M.; Gryko, R.; Mizak, L.; Malm, A. Bacteriophages as an alternative strategy for fighting biofilm development. Pol. J. Microbiol. 2014, 63, 137–145. [Google Scholar] [CrossRef] [PubMed]
- Mousavi, S.M.; Babakhani, S.; Moradi, L.; Karami, S.; Shahbandeh, M.; Mirshekar, M.; Mohebi, S.; Moghadam, M.T. Bacteriophage as a Novel Therapeutic Weapon for Killing Colistin-Resistant Multi-Drug-Resistant and Extensively Drug-Resistant Gram-Negative Bacteria. Curr. Microbiol. 2021, 78, 4023–4036. [Google Scholar] [CrossRef] [PubMed]
- Lin, N.T.; Chiou, P.Y.; Chang, K.C.; Chen, L.K.; Lai, M.J. Isolation and characterization of phi AB2: A novel bacteriophage of Acinetobacter baumannii. Res. Microbiol. 2010, 161, 308–314. [Google Scholar] [CrossRef]
- Chang, K.C.; Lin, N.T.; Hu, A.; Lin, Y.S.; Chen, L.K.; Lai, M.J. Genomic analysis of bacteriophage varphiAB1, a varphiKMV-like virus infecting multidrug-resistant Acinetobacter baumannii. Genomics 2011, 97, 249–255. [Google Scholar] [CrossRef] [PubMed] [Green Version]
- Yang, Z.; Liu, X.; Shi, Y.; Yin, S.; Shen, W.; Chen, J.; Chen, Y.; Chen, Y.; You, B.; Gong, Y.; et al. Characterization and genome annotation of a newly detected bacteriophage infecting multidrug-resistant Acinetobacter baumannii. Arch. Virol. 2019, 164, 1527–1533. [Google Scholar] [CrossRef] [PubMed] [Green Version]
- Vukotic, G.; Obradovic, M.; Novovic, K.; Di Luca, M.; Jovcic, B.; Fira, D.; Neve, H.; Kojic, M.; McAuliffe, O. Characterization, Antibiofilm, and Depolymerizing Activity of Two Phages Active on Carbapenem-Resistant Acinetobacter baumannii. Front. Med. 2020, 7, 426. [Google Scholar] [CrossRef] [PubMed]
- Ebrahimi, S.; Sisakhtpour, B.; Mirzaei, A.; Karbasizadeh, V.; Moghim, S. Efficacy of isolated bacteriophage against biofilm embedded colistin-resistant Acinetobacter baumanni. Gene Rep. 2021, 22, 100984. [Google Scholar] [CrossRef]
- Jeon, J.; Park, J.H.; Yong, D. Efficacy of bacteriophage treatment against carbapenem-resistant Acinetobacter baumannii in Galleria mellonella larvae and a mouse model of acute pneumonia. BMC Microbiol. 2019, 19, 70. [Google Scholar] [CrossRef]
- Yin, S.; Huang, G.; Zhang, Y.; Jiang, B.; Yang, Z.; Dong, Z.; You, B.; Yuan, Z.; Hu, F.; Zhao, Y.; et al. Phage Abp1 Rescues Human Cells and Mice from Infection by Pan-Drug Resistant Acinetobacter baumannii. Cell. Physiol. Biochem. 2017, 44, 2337–2345. [Google Scholar] [CrossRef] [PubMed]
- LaVergne, S.; Hamilton, T.; Biswas, B.; Kumaraswamy, M.; Schooley, R.T.; Wooten, D. Phage Therapy for a Multidrug-Resistant Acinetobacter baumannii Craniectomy Site Infection. Open Forum Infect. Dis. 2018, 5, ofy064. [Google Scholar] [CrossRef] [Green Version]
- Schooley, R.T.; Biswas, B.; Gill, J.J.; Hernandez-Morales, A.; Lancaster, J.; Lessor, L.; Barr, J.J.; Reed, S.L.; Rohwer, F.; Benler, S.; et al. Development and Use of Personalized Bacteriophage-Based Therapeutic Cocktails to Treat a Patient with a Disseminated Resistant Acinetobacter baumannii Infection. Antimicrob. Agents Chemother. 2017, 61, e00954-17. [Google Scholar] [CrossRef] [Green Version]
- Soimee, W.; Nakyai, W.; Charoensit, P.; Grandmottet, F.; Worasakwutiphong, S.; Phimnuan, P.; Viyoch, J. Evaluation of moisturizing and irritation potential of sacha inchi oil. J. Cosmet. Dermatol. 2020, 19, 915–924. [Google Scholar] [CrossRef]
- Aguilar, J.L.; Dávila, P.S.R.; Lozada-Requena, I.A.; Cabello, M.A. Comparative evaluation of the anti-inflammatory effect of two varieties of “Sacha Inchi” (Plukenetia volubilis and Plukenetia huayllabambana) in mice. In Frontiers in Immunology, Proceedings of the IMMUNOCOLOMBIA2015—11th Congress of the Latin American Association of Immunology, Medellin, Columbia, 13–16 October 2015; Frontiers Media SA: Lausanne, Switzerland, 2015. [Google Scholar] [CrossRef]
- Gonzalez-Aspajo, G.; Belkhelfa, H.; Haddioui-Hbabi, L.; Bourdy, G.; Deharo, E. Sacha Inchi Oil (Plukenetia volubilis L.), effect on adherence of Staphylococus aureus to human skin explant and keratinocytes in vitro. J. Ethnopharmacol. 2015, 171, 330–334. [Google Scholar] [CrossRef] [PubMed]
- Kiattiphumi Saengsorn, A.J. Determination of hydrophilic–lipophilic balance value and emulsion properties of sacha inchi oil. Asian Pac. J. Trop. Biomed. 2017, 7, 1092–1096. [Google Scholar] [CrossRef]
- Viazis, S.; Akhtar, M.; Feirtag, J.; Brabban, A.D.; Diez-Gonzalez, F. Isolation and characterization of lytic bacteriophages against enterohaemorrhagic Escherichia coli. J. Appl. Microbiol. 2011, 110, 1323–1331. [Google Scholar] [CrossRef]
- Aziz, R.K.; Bartels, D.; Best, A.A.; DeJongh, M.; Disz, T.; Edwards, R.A.; Formsma, K.; Gerdes, S.; Glass, E.M.; Kubal, M.; et al. The RAST Server: Rapid annotations using subsystems technology. BMC Genomics 2008, 9, 75. [Google Scholar] [CrossRef] [Green Version]
- Nishimura, Y.; Yoshida, T.; Kuronishi, M.; Uehara, H.; Ogata, H.; Goto, S. ViPTree: The viral proteomic tree server. Bioinformatics 2017, 33, 2379–2380. [Google Scholar] [CrossRef] [PubMed]
- Grant, J.R.; Stothard, P. The CGView Server: A comparative genomics tool for circular genomes. Nucleic Acids Res. 2008, 36, W181–W184. [Google Scholar] [CrossRef] [PubMed]
- Altschul, S.F.; Gish, W.; Miller, W.; Myers, E.W.; Lipman, D.J. Basic local alignment search tool. J. Mol. Biol. 1990, 215, 403–410. [Google Scholar] [CrossRef]
- Meier-Kolthoff, J.P.; Goker, M. VICTOR: Genome-based phylogeny and classification of prokaryotic viruses. Bioinformatics 2017, 33, 3396–3404. [Google Scholar] [CrossRef] [Green Version]
- Fernandez-Ruiz, I.; Coutinho, F.H.; Rodriguez-Valera, F. Thousands of Novel Endolysins Discovered in Uncultured Phage Genomes. Front. Microbiol. 2018, 9, 1033. [Google Scholar] [CrossRef] [PubMed] [Green Version]
- Schmelcher, M.; Donovan, D.M.; Loessner, M.J. Bacteriophage endolysins as novel antimicrobials. Future Microbiol. 2012, 7, 1147–1171. [Google Scholar] [CrossRef] [Green Version]
- Jones, D.T.; Taylor, W.R.; Thornton, J.M. The rapid generation of mutation data matrices from protein sequences. Comput. Appl. Biosci. 1992, 8, 275–282. [Google Scholar] [CrossRef]
- Drago, L.; De Vecchi, E.; Nicola, L.; Gismondo, M.R. In vitro evaluation of antibiotics’ combinations for empirical therapy of suspected methicillin resistant Staphylococcus aureus severe respiratory infections. BMC Infect. Dis. 2007, 7, 111. [Google Scholar] [CrossRef] [Green Version]
- Lin, M.F.; Lan, C.Y. Antimicrobial resistance in Acinetobacter baumannii: From bench to bedside. World J. Clin. Cases 2014, 2, 787–814. [Google Scholar] [CrossRef]
- Nocera, F.P.; Attili, A.R.; De Martino, L. Acinetobacter baumannii: Its Clinical Significance in Human and Veterinary Medicine. Pathogens 2021, 10, 127. [Google Scholar] [CrossRef]
- Ibrahim, S.; Al-Saryi, N.; Al-Kadmy, I.M.S.; Aziz, S.N. Multidrug-resistant Acinetobacter baumannii as an emerging concern in hospitals. Mol. Biol. Rep. 2021, 48, 6987–6998. [Google Scholar] [CrossRef]
- Lee, C.R.; Lee, J.H.; Park, M.; Park, K.S.; Bae, I.K.; Kim, Y.B.; Cha, C.J.; Jeong, B.C.; Lee, S.H. Biology of Acinetobacter baumannii: Pathogenesis, Antibiotic Resistance Mechanisms, and Prospective Treatment Options. Front. Cell. Infect. Microbiol. 2017, 7, 55. [Google Scholar] [CrossRef] [Green Version]
- Meletis, G. Carbapenem resistance: Overview of the problem and future perspectives. Ther. Adv. Infect. Dis. 2016, 3, 15–21. [Google Scholar] [CrossRef] [Green Version]
- Sun, J.; Chen, C.; Cui, C.Y.; Zhang, Y.; Liu, X.; Cui, Z.H.; Ma, X.Y.; Feng, Y.; Fang, L.X.; Lian, X.L.; et al. Plasmid-encoded tet(X) genes that confer high-level tigecycline resistance in Escherichia coli. Nat. Microbiol. 2019, 4, 1457–1464. [Google Scholar] [CrossRef] [PubMed]
- Lang, L.H. FDA Approves Use of Bacteriophages to be Added to Meat and Poultry Products. Gastroenterol. Hepatol. News 2006, 131, 1370. [Google Scholar] [CrossRef]
- Bren, L. Bacteria-eating virus approved as food additive. FDA Consum. 2007, 41, 20–22. [Google Scholar]
- Goodridge, L.D.; Bisha, B. Phage-based biocontrol strategies to reduce foodborne pathogens in foods. Bacteriophage 2011, 1, 130–137. [Google Scholar] [CrossRef] [PubMed] [Green Version]
- Bloch, S.; Nejman-Faleńczyk, B.; Topka, G.; Dydecka, A.; Licznerska, K.; Narajczyk, M.; Necel, A.; Węgrzyn, A.; Węgrzyn, G. UV-Sensitivity of Shiga Toxin-Converting Bacteriophage Virions Φ24B, 933W, P22, P27 and P32. Toxins 2015, 7, 3727–3739. [Google Scholar] [CrossRef] [PubMed]
- Alic, S.; Naglic, T.; Tusek-Znidaric, M.; Ravnikar, M.; Racki, N.; Peterka, M.; Dreo, T. Newly Isolated Bacteriophages from the Podoviridae, Siphoviridae, and Myoviridae Families Have Variable Effects on Putative Novel Dickeya spp. Front. Microbiol. 2017, 8, 1870. [Google Scholar] [CrossRef] [PubMed]
- Wintachai, P.; Naknaen, A.; Thammaphet, J.; Pomwised, R.; Phaonakrop, N.; Roytrakul, S.; Smith, D.R. Characterization of extended-spectrum-beta-lactamase producing Klebsiella pneumoniae phage KP1801 and evaluation of therapeutic efficacy in vitro and in vivo. Sci. Rep. 2020, 10, 11803. [Google Scholar] [CrossRef]
- Schwalfenberg, G.K. The alkaline diet: Is there evidence that an alkaline pH diet benefits health? J. Environ. Public Health 2012, 2012, 727630. [Google Scholar] [CrossRef]
- Oechslin, F. Resistance Development to Bacteriophages Occurring during Bacteriophage Therapy. Viruses 2018, 10, 351. [Google Scholar] [CrossRef] [PubMed] [Green Version]
- Wang, Z.; Cai, R.; Wang, G.; Guo, Z.; Liu, X.; Guan, Y.; Ji, Y.; Zhang, H.; Xi, H.; Zhao, R.; et al. Combination Therapy of Phage vB_KpnM_P-KP2 and Gentamicin Combats Acute Pneumonia Caused by K47 Serotype Klebsiella pneumoniae. Front. Microbiol. 2021, 12, 674068. [Google Scholar] [CrossRef]
- Wintachai, P.; Surachat, K.; Singkhamanan, K. Isolation and Characterization of a Novel Autographiviridae Phage and Its Combined Effect with Tigecycline in Controlling Multidrug-Resistant Acinetobacter baumannii-Associated Skin and Soft Tissue Infections. Viruses 2022, 14, 194. [Google Scholar] [CrossRef]
- Rossiter, S.E.; Fletcher, M.H.; Wuest, W.M. Natural Products as Platforms To Overcome Antibiotic Resistance. Chem. Rev. 2017, 117, 12415–12474. [Google Scholar] [CrossRef] [PubMed]
- Khoramnia, A.; Ebrahimpour, A.; Ghanbari, R.; Ajdari, Z.; Lai, O.M. Improvement of medium chain fatty acid content and antimicrobial activity of coconut oil via solid-state fermentation using a Malaysian Geotrichum candidum. BioMed Res. Int. 2013, 2013, 954542. [Google Scholar] [CrossRef] [Green Version]
- Widianingrum, D.C.; Noviandi, C.T.; Salasia, S.I.O. Antibacterial and immunomodulator activities of virgin coconut oil (VCO) against Staphylococcus aureus. Heliyon 2019, 5, e02612. [Google Scholar] [CrossRef] [Green Version]
- Sechi, L.A.; Lezcano, I.; Nunez, N.; Espim, M.; Dupre, I.; Pinna, A.; Molicotti, P.; Fadda, G.; Zanetti, S. Antibacterial activity of ozonized sunflower oil (Oleozon). J. Appl. Microbiol. 2001, 90, 279–284. [Google Scholar] [CrossRef] [Green Version]
- Ni, P.; Wang, L.; Deng, B.; Jiu, S.; Ma, C.; Zhang, C.; Almeida, A.; Wang, D.; Xu, W.; Wang, S. Combined Application of Bacteriophages and Carvacrol in the Control of Pseudomonas syringae pv. actinidiae Planktonic and Biofilm Forms. Microorganisms 2020, 8, 837. [Google Scholar] [CrossRef]
- Castro, J.P.; Vaca, C.F.; Soto, E.J.; Vargas, J.R.; García, G.; Bañon, J.; Neira, E.F.; Tuesta, T. Sacha inchi oil (Plukenetia volubilis) stabilized with antioxidants for addition in fresh cheese. Afr. J. Food Agric. Nutr. Dev. 2020, 20, 16638–16651. [Google Scholar] [CrossRef]
- Cisneros, F.H.; Paredes, D.; Arana, A.; Cisneros-Zevallos, L. Chemical composition, oxidative stability and antioxidant capacity of oil extracted from roasted seeds of Sacha-inchi (Plukenetia volubilis L.). J. Agric. Food Chem. 2014, 62, 5191–5197. [Google Scholar] [CrossRef] [PubMed]
- Ramos-Escudero, F.; Munoz, A.M.; Ramos Escudero, M.; Vinas-Ospino, A.; Morales, M.T.; Asuero, A.G. Characterization of commercial Sacha inchi oil according to its composition: Tocopherols, fatty acids, sterols, triterpene and aliphatic alcohols. J. Food Sci. Technol. 2019, 56, 4503–4515. [Google Scholar] [CrossRef]
- Jończyk, E.; Kłak, M.; Międzybrodzki, R.; Górski, A. The influence of external factors on bacteriophage. Folia Microbiol. 2011, 56, 191–200. [Google Scholar] [CrossRef] [Green Version]
- Al Samawi, M.S.; Khan, F.Y.; Eldeeb, Y.; Almaslamani, M.; Alkhal, A.; Alsoub, H.; Ghadban, W.; Howady, F.; Hashim, S. Acinetobacter Infections among Adult Patients in Qatar: A 2-Year Hospital-Based Study. Can. J. Infect. Dis. Med. Microbiol. 2016, 2016, 6873689. [Google Scholar] [CrossRef] [PubMed] [Green Version]
- Ali, A.; Botha, J.; Tiruvoipati, R. Fatal skin and soft tissue infection of multidrug resistant Acinetobacter baumannii: A case report. Int. J. Surg. Case Rep. 2014, 5, 532–536. [Google Scholar] [CrossRef] [Green Version]
- Desbois, A.P.; Smith, V.J. Antibacterial free fatty acids: Activities, mechanisms of action and biotechnological potential. Appl. Microbiol. Biotechnol. 2010, 85, 1629–1642. [Google Scholar] [CrossRef] [Green Version]
- Raorane, C.J.; Lee, J.H.; Kim, Y.G.; Rajasekharan, S.K.; Garcia-Contreras, R.; Lee, J. Antibiofilm and Antivirulence Efficacies of Flavonoids and Curcumin Against Acinetobacter baumannii. Front. Microbiol. 2019, 10, 990. [Google Scholar] [CrossRef]
- Ulusoy, S.; Bosgelmez-Tinaz, G.; Secilmis-Canbay, H. Tocopherol, carotene, phenolic contents and antibacterial properties of rose essential oil, hydrosol and absolute. Curr. Microbiol. 2009, 59, 554–558. [Google Scholar] [CrossRef]
- Kodicek, E. The effect of unsaturated fatty acids on Lactobacillus helveticus and other Gram-positive micro-organisms. Biochem. J. 1945, 39, 78–85. [Google Scholar] [CrossRef] [PubMed] [Green Version]
- Nzogong, R.T.; Ndjateu, F.S.T.; Ekom, S.E.; Fosso, J.M.; Awouafack, M.D.; Tene, M.; Tane, P.; Morita, H.; Choudhary, M.I.; Tamokou, J.D. Antimicrobial and antioxidant activities of triterpenoid and phenolic derivatives from two Cameroonian Melastomataceae plants: Dissotis senegambiensis and Amphiblemma monticola. BMC Complement. Altern. Med. 2018, 18, 159. [Google Scholar] [CrossRef] [PubMed]
- Wintachai, P.; Phaonakrop, N.; Roytrakul, S.; Naknaen, A.; Pomwised, R.; Voravuthikunchai, S.P.; Surachat, K.; Smith, D.R. Enhanced antibacterial effect of a novel Friunavirus phage vWU2001 in combination with colistin against carbapenem-resistant Acinetobacter baumannii. Sci. Rep. 2022, 12, 1–19. [Google Scholar] [CrossRef] [PubMed]
- Seemann, T. Prokka: Rapid prokaryotic genome annotation. Bioinformatics 2014, 30, 2068–2069. [Google Scholar] [CrossRef] [PubMed]
- Wintachai, P.; Naknaen, A.; Pomwised, R.; Voravuthikunchai, S.P.; Smith, D.R. Isolation and characterization of Siphoviridae phage infecting extensively drug-resistant Acinetobacter baumannii and evaluation of therapeutic efficacy in vitro and in vivo. J. Med. Microbiol. 2019, 68, 1096–1108. [Google Scholar] [CrossRef] [PubMed]
- Mirzaei, M.K.; Nilsson, A.S. Correction: Isolation of phages for phage therapy: A comparison of spot tests and efficiency of plating analyses for determination of host range and efficacy. PLoS ONE 2015, 10, e0127606. [Google Scholar] [CrossRef] [PubMed] [Green Version]
- Bankevich, A.; Nurk, S.; Antipov, D.; Gurevich, A.A.; Dvorkin, M.; Kulikov, A.S.; Lesin, V.M.; Nikolenko, S.I.; Pham, S.; Prjibelski, A.D.; et al. SPAdes: A new genome assembly algorithm and its applications to single-cell sequencing. J. Comput. Biol. 2012, 19, 455–477. [Google Scholar] [CrossRef] [Green Version]
- Joensen, K.G.; Scheutz, F.; Lund, O.; Hasman, H.; Kaas, R.S.; Nielsen, E.M.; Aarestrup, F.M. Real-time whole-genome sequencing for routine typing, surveillance, and outbreak detection of verotoxigenic Escherichia coli. J. Clin. Microbiol. 2014, 52, 1501–1510. [Google Scholar] [CrossRef] [PubMed] [Green Version]
- Chan, P.P.; Lowe, T.M. tRNAscan-SE: Searching for tRNA Genes in Genomic Sequences. Methods Mol. Biol. 2019, 1962, 1–14. [Google Scholar] [CrossRef]
- Meier-Kolthoff, J.P.; Auch, A.F.; Klenk, H.P.; Goker, M. Genome sequence-based species delimitation with confidence intervals and improved distance functions. BMC Bioinform. 2013, 14, 60. [Google Scholar] [CrossRef] [Green Version]
- Lefort, V.; Desper, R.; Gascuel, O. FastME 2.0: A Comprehensive, Accurate, and Fast Distance-Based Phylogeny Inference Program. Mol. Biol. Evol. 2015, 32, 2798–2800. [Google Scholar] [CrossRef] [Green Version]
- Meier-Kolthoff, J.P.; Hahnke, R.L.; Petersen, J.; Scheuner, C.; Michael, V.; Fiebig, A.; Rohde, C.; Rohde, M.; Fartmann, B.; Goodwin, L.A.; et al. Complete genome sequence of DSM 30083(T), the type strain (U5/41(T)) of Escherichia coli, and a proposal for delineating subspecies in microbial taxonomy. Stand. Genomic Sci. 2014, 9, 2. [Google Scholar] [CrossRef] [PubMed] [Green Version]
- Goker, M.; Garcia-Blazquez, G.; Voglmayr, H.; Telleria, M.T.; Martin, M.P. Molecular taxonomy of phytopathogenic fungi: A case study in Peronospora. PLoS ONE 2009, 4, e6319. [Google Scholar] [CrossRef] [Green Version]
- Kropinski, A.M. Practical Advice on the One-Step Growth Curve. Methods Mol. Biol. 2018, 1681, 41–47. [Google Scholar] [CrossRef]
- Wintachai, P.; Paosen, S.; Yupanqui, C.T.; Voravuthikunchai, S.P. Silver nanoparticles synthesized with Eucalyptus critriodora ethanol leaf extract stimulate antibacterial activity against clinically multidrug-resistant Acinetobacter baumannii isolated from pneumonia patients. Microb. Pathog. 2019, 126, 245–257. [Google Scholar] [CrossRef] [PubMed]
- Clinical and Laboratory Standards Intitute. M07-A8-Methods for Dilution Antimicrobial Susceptibility Test for Bacteria That Grow Aerobically Approved Standard-Eight Edition; Clinical and Laboratory Standards Intitute: Wayne, PA, USA, 2009. [Google Scholar]

| Strain | Phage vWUPSU | |
|---|---|---|
| Lytic Activity | EOP | |
| MDR A. baumannii NPRCOE 160516 | − | − |
| MDR A. baumannii NPRCOE 160517 | + | Low productive (0.08) |
| MDR A. baumannii NPRCOE 160518 | − | − |
| MDR A. baumannii NPRCOE 160519 | + | High (Host = 1) |
| MDR A. baumannii NPRCOE 160520 | − | − |
| MDR A. baumannii NPRCOE 160521 | + | Medium productive (0.25) |
| MDR A. baumannii NPRCOE 160522 | − | − |
| MDR A. baumannii NPRCOE 160523 | − | − |
| MDR A. baumannii NPRCOE 160524 | + | Medium productive (0.43) |
| MDR A. baumannii NPRCOE 160525 | − | − |
| MDR A. baumannii NPRCOE 160526 | + | High productive (0.63) |
| MDR A. baumannii NPRCOE 160527 | + | Low productive(0.09) |
| MDR A. baumannii NPRCOE 160528 | + | High productive (0.75) |
| MDR A. baumannii NPRCOE 160529 | + | Medium productive (0.29) |
| MDR A. baumannii NPRCOE 160530 | − | − |
| MDR A. baumannii NPRCOE 160531 | + | High productive (0.77) |
| MDR A. baumannii NPRCOE 160532 | + | Low productive(0.04) |
| MDR A. baumannii NPRCOE 160533 | − | − |
| MDR A. baumannii NPRCOE 160534 | − | − |
| MDR A. baumannii NPRCOE 160535 | − | − |
| MDR A. baumannii NPRCOE 160536 | + | High productive (0.73) |
| MDR A. baumannii NPRCOE 160537 | + | Medium productive (0.1) |
| MDR A. baumannii NPRCOE 160538 | − | − |
| MDR A. baumannii NPRCOE 160539 | − | − |
| MDR A. baumannii NPRCOE 160540 | + | Medium productive (0.14) |
| MDR A. baumannii NPRCOE 160541 | + | High productive (0.63) |
| MDR A. baumannii NPRCOE 160542 | + | High productive (0.84) |
| MDR A. baumannii NPRCOE 160543 | − | − |
| MDR A. baumannii NPRCOE 160544 | + | Medium productive (0.11) |
| MDR A. baumannii NPRCOE 160545 | − | − |
| E. coli | − | − |
| K. pneumoniae | − | − |
| MRSA | − | − |
| P. aeruginosa | − | − |
Publisher’s Note: MDPI stays neutral with regard to jurisdictional claims in published maps and institutional affiliations. |
© 2022 by the authors. Licensee MDPI, Basel, Switzerland. This article is an open access article distributed under the terms and conditions of the Creative Commons Attribution (CC BY) license (https://creativecommons.org/licenses/by/4.0/).
Share and Cite
Wintachai, P.; Voravuthikunchai, S.P. Characterization of Novel Lytic Myoviridae Phage Infecting Multidrug-Resistant Acinetobacter baumannii and Synergistic Antimicrobial Efficacy between Phage and Sacha Inchi Oil. Pharmaceuticals 2022, 15, 291. https://doi.org/10.3390/ph15030291
Wintachai P, Voravuthikunchai SP. Characterization of Novel Lytic Myoviridae Phage Infecting Multidrug-Resistant Acinetobacter baumannii and Synergistic Antimicrobial Efficacy between Phage and Sacha Inchi Oil. Pharmaceuticals. 2022; 15(3):291. https://doi.org/10.3390/ph15030291
Chicago/Turabian StyleWintachai, Phitchayapak, and Supayang Piyawan Voravuthikunchai. 2022. "Characterization of Novel Lytic Myoviridae Phage Infecting Multidrug-Resistant Acinetobacter baumannii and Synergistic Antimicrobial Efficacy between Phage and Sacha Inchi Oil" Pharmaceuticals 15, no. 3: 291. https://doi.org/10.3390/ph15030291
APA StyleWintachai, P., & Voravuthikunchai, S. P. (2022). Characterization of Novel Lytic Myoviridae Phage Infecting Multidrug-Resistant Acinetobacter baumannii and Synergistic Antimicrobial Efficacy between Phage and Sacha Inchi Oil. Pharmaceuticals, 15(3), 291. https://doi.org/10.3390/ph15030291
